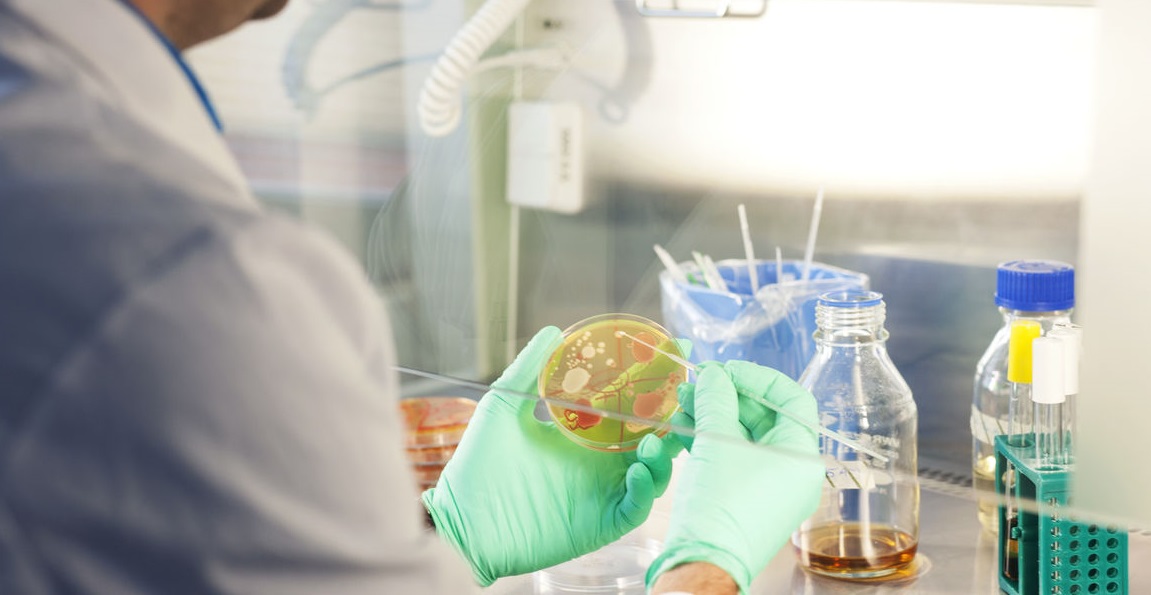
image placeholder

Los fondos de capital de riesgo apuntan a la economía del conocimiento y la Argentina pierde estas oportunidades
:quality(75):max_bytes(102400)/https://assets.iprofesional.com/assets/jpg/2019/07/480970.jpg)
La Argentina va a contramano del mundo. Mientras los fondos de capital de riesgo siguen activos a pesar de la pandemia y se concentran en fintech, agricultura, biotecnología, software, farmacéutica y automotriz , en donde se desembolsaron u$s62.900 millones en el segundo trimestre de 2020, en este país continúa sin definirse el futuro de la ley de economía del conocimiento que impulsaría el desarrollo de varios de esos sectores que traccionan inversiones en el mundo.
Estados Unidos capitalizó más de la mita de la inversión de riesgo del mundo en este lapso, al lograr fondeos por u$s34.300 millones por medio de 2.197 acuerdos, sobre un total de 4.502 celebrados, de acuerdo a datos de KPMG.
En la región, Brasil y México fueron los otros países que concentraron parte de esos financiamiento aunque con porcentajes muy menores. Si lo captado por Estados Unidos se traslada a la región, se advierte que nucleó el 97% del dinero disponible a esos proyectos. Brasil logró el 0,7% mientras que México obtuvo un 0,1%. Ambos países atrajeron el interés por u$s260 millones.
¿En qué empresas se concentraron estas inyecciones de capital de riesgo? En compañías chinas y estadounidenses, una muestra más de la competencia entre estas potencias por el poderío geopolítico. Waymo, la empresa de Google dedicada al desarrollo de autos autónomos, capturó u$s3.000 millones, seguida por MGI Tech, de Shenzhen, que desarrolla soluciones para la secuenciación del genoma y se orienta a las ciencias de la vida y logró u$s1.000 millones.
Otra china logró el mismo nivel de capitalización. Se trata de DiDi Bike que, con sede en Hangzhoy, desarrolla diversas soluciones de movilidad, desde bicicletas hasta taxis pero también apunta a la inclusión financiera.

Stripe, dedicada al procesamiento de pagos online, con sede en San Francisco, concentró u$s850 millones, mientras que otra china, Zuoyebang, que brinda servicios de educación on line para estudiantes de primaria y secundaria, capturó u$s750 millones.
Más allá de las restricciones que impuso la pandemia en todo el planeta y de los cambios acelerados que produjo en términos de adopción digital los capitales de riesgo siguen ávidos por apostar a aquellas empresas que vienen haciendo investigación en nuevas tecnologías y comportamientos sociales además de las que mejor paradas quedarán en función de la nueva normalidad: la movilidad, la biotecnología, los servicios financieros y la educación serán sin dudas los segmentos que experimentarán nuevos avances hacia adelante.
Biotecnología con una buena
Parte de estos sectores son los que están incluidos en la ley de economía del conocimiento, cuya aprobación en el Senado quedó obstaculizada una vez que ingresó al Congreso el proyecto de reforma judicial. La biotecnología entre ellos, aunque esta industria –que ya venía promocionada- recibió una buena noticia esta semana.
El ministerio de Desarrollo Productivo abrió la convoatoria para acceder a los beneficios del régimen de promoción de biotecnología que otorga beneficios fiscales a los proyectos de investigación y desarrollo que prioricen las exportaciones, la contratación de personal altamente calificado y los desarrollos biotecnológicos orientados a mitigar los efectos generados por la pandemia de covid-19.
La convocatoria de este nuevo régimen de promoción se publicó en el Boletín Oficial mediante la disposición 1/2020, se enmarca dentro de la ley 26.270 de promoción de la biotecnología moderna, y está abierta hasta el 19 de octubre o agotar el cupo fiscal de $200 millones previsto por el gobierno.
La relevancia de estos sectores para los principales países del mundo es de tal envergadura que los inversores de Estados Unidos fueron los que más se interesaron por él en el segundo trimestre del año.
La empresa Grail, que realiza test para detectar cáncer antes de que aparezcan los síntomas, recaudó u$s390 millones, y el desarrollador de fármacos Erasca, también dedicada a investigaciones para "erradicar el cáncer" obtuvo u$s200 millones.
Si bien estos sectores ya habían estado en el radar de los inversores de capital de riesgo en los últimos trimestres, la pandemia ha hecho que los inversores concentren su atención en ellos, indicó el informe de KPMG.
"La inversión en capital de riesgo en Brasil cayó drásticamente en el segundo trimestre, impulsada por los desafíos impuestos por la COVID-19. No obstante, el sector de delivery fue una excepción, con la fintech CargoX que recaudó US$ 80 millones. Claramente, el espacio fintech continúa representando una oportunidad en la región, y a pesar de la crisis que estamos viviendo", explicó Ricardo Anhesini, socio líder de private equity de KPMG en América del Sur para quien todavía no puede evaluarse el impacto que el coronavirus terminará produciendo en la región.
Lo que sí está claro es que los fondos de capital de riesgo buscan empresas que atienden las necesidades sanitarias que produjo el covid-19 al mismo nivel que cualquier otros segmentos dentro de las ciencias de la vida.
A ello se suman aquellas firmas con modelos de negocios considerados relevantes y escalables para satisfacer las necesidades de los consumidores y las empresas dentro de la "nueva normalidad", como aquellas enfocadas en productividad B2B, ciberseguridad, servicios digitales y comercio electrónico.